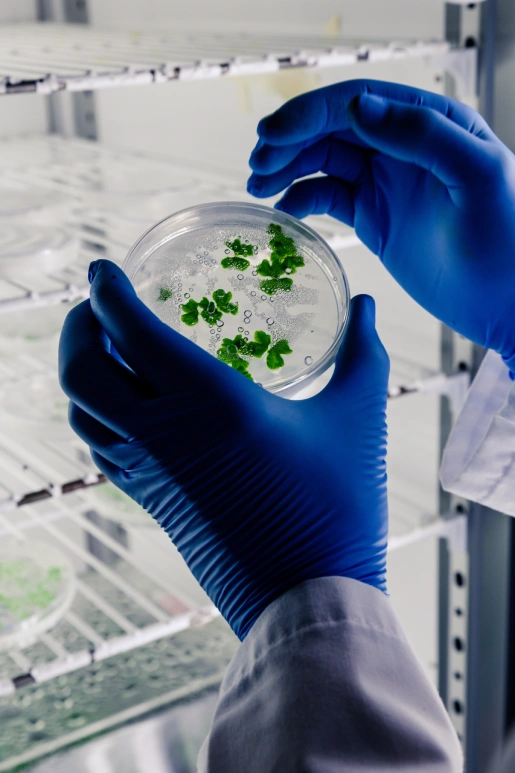
Un equipo de expertos siempre listos para ti - LaCardio

Contamos con un equipo de médicos especialistas orientados a la atención de la salud en la genética y enfermedades de la herencia con alta calidad, humanismo y ética.

NUESTRO EQUIPO
TRATAMIENTOS EN GENÉTICA
Anomalías y/o deformidades congénitas.
Cardiopatías congénitas y hereditarias.
Cromosomopatías.
Enfermedades neuromusculares y neurodegenerativas.
Errores innatos del metabolismo.
Inmunodeficiencias primarias.
Trastornos del desarrollo de la diferenciación sexual.
Genética del cáncer.
Asesoramiento genético al paciente y su familia.
Asesoramiento genético preconcepcional y prenatal.
Asesoramiento genético en cáncer hereditario.
Asesoramiento en interpretación de resultados y solicitud de exámenes de laboratorio relacionados con la Genética Humana.
EQUIPO DE TRABAJO, GENÉTICA


Gracias por confiar en nosotros.
Hemos recibido tu información y uno de nuestros asesores se pondrá en contacto contigo lo antes posible para confirmar los detalles de tu cita médica.
Mientras tanto, si tienes alguna inquietud o deseas actualizar tu solicitud, puedes comunicarte con nosotros a través de nuestros canales de atención.
Nuestro compromiso es cuidar de ti y de quienes más quieres.